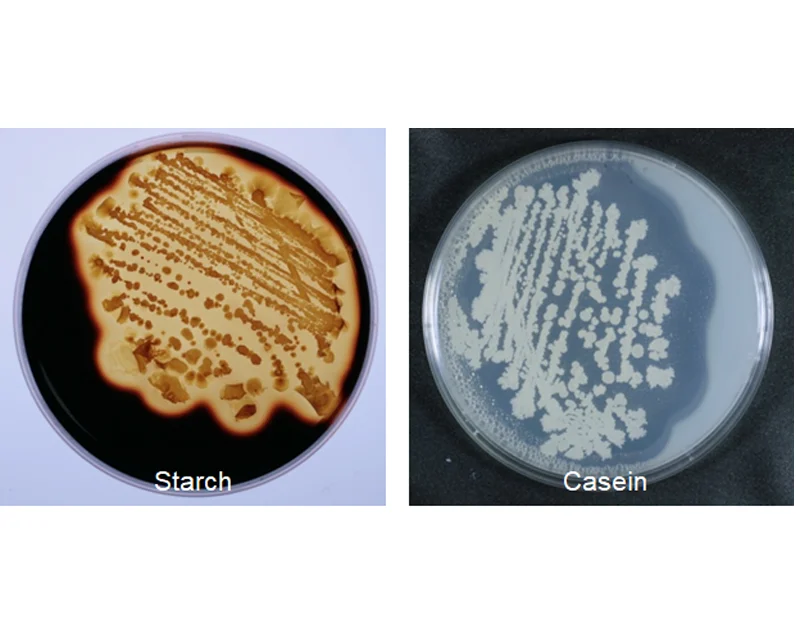
Japanese Mixture Animal Premix Shrimp Feed Additives For Fish

Japanese Mixture Animal Premix Shrimp Feed Additives For Fish
- Category: >>>
- Supplier: Kyushu Medical Co. Ltd.
Share on (11000000068367):
Product Overview
Description
Products Description

ARIAKE1 is a biological product that contains Bacillus amyloliquefaciens strain D203 as an active ingredient. The strain D203 shows strong enzymatic activities to degrade pollutants from daily operation in aquaculture. This product has been used as feed material in a feed mill company in Japan for more than 10 years. This biological product can be helpful to keep the sustainable culture condition for fish and shrimp in a farming area in an eco-friendly way.
Product Name | ARIAKE1 |
Brand Name | BioJan |
Place Of Origin | Japan |

Specification
Usage: Feed supplement for aquaculture
Active ingredient: Bacillus amyloliquefaciens D203 1x107 ~1×109 CFU/g
Other ingredient: Calcium carbonate, Starch
Form: Powder
Grade:Feed
Packing: 1kg/bag, 10kg/bag, 20kg/bag
Certificate: ISO9001:2015
Shelf life: 24 months after a manufacturing month
Origin: Japan
Usage: Feed supplement for aquaculture
Active ingredient: Bacillus amyloliquefaciens D203 1x107 ~1×109 CFU/g
Other ingredient: Calcium carbonate, Starch
Form: Powder
Grade:Feed
Packing: 1kg/bag, 10kg/bag, 20kg/bag
Certificate: ISO9001:2015
Shelf life: 24 months after a manufacturing month
Origin: Japan
Function
Accumulation of undigested feed is the main pollution source in the cultural environment.The pollution causes excess sludge which shows toxic to farmed fish and shrimp.The strain D203 can reduce pollution with its strong enzymatic activities.The D203 exhibits enzymatic activities against main organic matters from a feed like protein,starch,and cellulose.

Spores of strain D203 eaten together with feed are finally released together with feces.Then after the spores germinate,they utilize undigested feed with their strong enzymatic activities aerobically.
How to use
0.1 to 0.2% (w/w) in feed (ex.1 to 2 kg per 1 metric ton of feed)


Acute toxicity information
Oral LD50 (Rat) > 2,000 mg/kg.
Dermal LD50 (Rat) > 2,000 mg/kg.
Inhalation LD50 (Rat) > 20 mg/kg.
Oral LD50 (Rat) > 2,000 mg/kg.
Dermal LD50 (Rat) > 2,000 mg/kg.
Inhalation LD50 (Rat) > 20 mg/kg.
Safety precautions
Store in a cool and dry place,avoiding direct sunlight.
Please use it with a quality preservation period (2 years after a manufacturing month).

For your evaluation
We are ready to give a free sample for your evaluation as long as you can pay for the shipping cost or have a collect/account No.for a courier like FedEx or DHL.But in that case,please check and confirm with the authorities concerned if you can import our sample into your country.
We are ready to give a free sample for your evaluation as long as you can pay for the shipping cost or have a collect/account No.for a courier like FedEx or DHL.But in that case,please check and confirm with the authorities concerned if you can import our sample into your country.
To meet your request
Different packages and labels can be accepted as required.
Quantity(Kilogram) | 1-1,000 | 1,001-5,000 | >5,000 | ||
Est. time (days) | 21 | 35 | To be negotiated | ||
Company Profile
Kyushu Medical Co., Ltd was established in 1987 as a pharmacy business. We have continued to grow, entering the biotechnology business in 1995.


With a passion to provide products that are truly effective, we are working from the screening of microbes to processed products in order to utilize the inherent ability of microbes. In 2005, we were awarded the Global 100 Eco-Tech Awards, as eco-friendly technologies that contribute to solving global environmental problems and to sustainability.

In 2020, we have acquired ISO 9001 certification for customer satisfaction and quality assurance.
We Recommend
New Arrivals
New products from manufacturers at wholesale prices